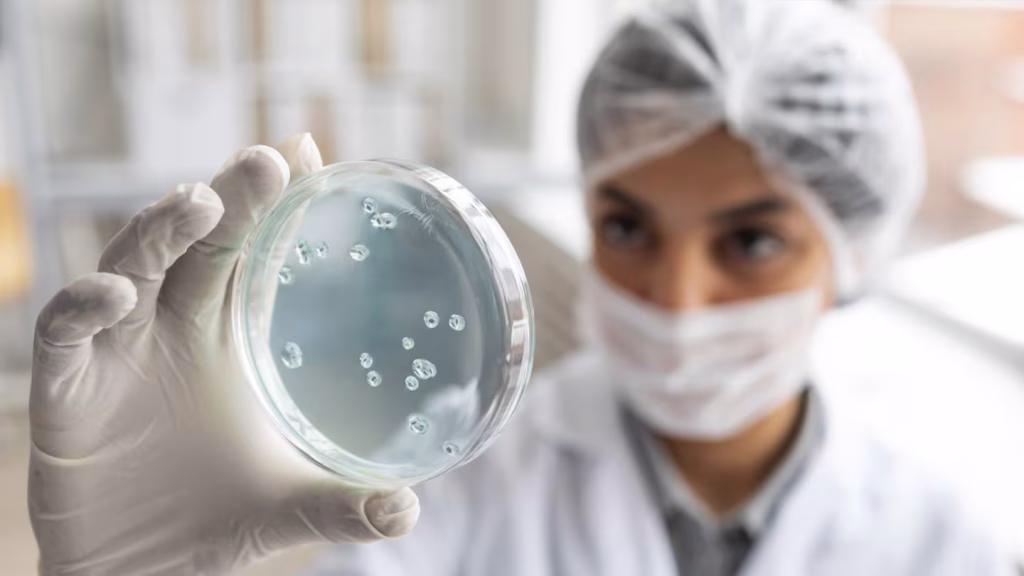

Cuando pensamos en lugares llenos de gérmenes, lo primero que se nos viene a la cabeza suele ser el baño o la cocina. Sin embargo, hay un artefacto que supera ampliamente a ambos: el celular.
Aunque muchos creen que el control remoto es el principal imán de microbios, la evidencia científica apunta hacia el dispositivo que más tocamos a lo largo del día.
Según distintas investigaciones, tanto la pantalla como la carcasa del teléfono son hábitats ideales para bacterias, entre ellas algunas potencialmente patógenas.
Un estudio realizado por investigadores de la Universidad de Tartu (Estonia) analizó los celulares de varios estudiantes y encontró altos niveles de contaminación bacteriana. En algunos casos, incluso se detectaron restos de materia fecal, una clara señal de mala higiene.
Por su parte, un trabajo publicado en la revista Nature demostró que los teléfonos móviles funcionan como verdaderos reservorios de microbios, entre ellos bacterias resistentes a los antibióticos y microorganismos asociados a enfermedades.

La diversidad bacteriana presente en cada dispositivo refleja, además, los lugares por donde circula su dueño y con quién estuvo en contacto.
En 2022, otro estudio de la misma revista advirtió que los celulares pueden actuar como “plataformas microbianas peligrosas”, capaces de facilitar contagios en brotes epidémicos si no se limpian de forma adecuada.
Qué bacterias viven en tu celular
- Bacterias de la piel: como Staphylococcus epidermidis, que normalmente viven en nuestro cuerpo.
- Potenciales patógenos: Staphylococcus aureus y enterobacterias, que pueden causar infecciones.
- Microorganismos resistentes a antibióticos: sobre todo en celulares usados en hospitales.
- Contaminantes fecales: un claro indicador de mala higiene.
La pantalla táctil es la parte más sucia, porque está en contacto directo con los dedos, la grasa y la humedad, que facilitan la adhesión de bacterias.
Cómo limpiar correctamente tu celular
- Toallitas desinfectantes con alcohol isopropílico al 70%: pasalas por la pantalla, la parte trasera y los bordes, evitando los puertos y parlantes. Lo ideal es hacerlo todos los días, sobre todo si usaste el celular fuera de casa.
- Paños de microfibra con alcohol: limpian sin dañar la pantalla y eliminan la grasa que ayuda a que se peguen los bichos.
- No apoyes el celular en superficies públicas: mesas de bares, baños o transporte público son focos de contaminación.
- Fundas y protectores antimicrobianos: ayudan, pero no eliminan todos los microorganismos.
- Lavate las manos con agua y jabón antes y después de usar el celular.
- No compartas el teléfono: cada vez que lo hacés, aumentás el riesgo de contagio.
- Exposición a luz ultravioleta (UV-C): algunos dispositivos usan esta tecnología para eliminar bacterias y virus en segundos.
- Desinfección profesional: en hospitales y lugares de alto riesgo, se recomienda una limpieza más profunda.
Fuente: TN